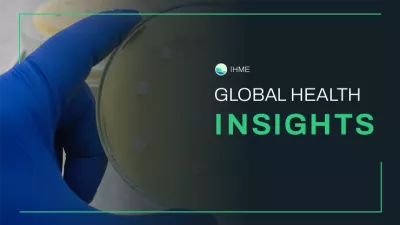
Global health insights

Antimicrobial resistance (AMR)
AMR poses a major threat to human health around the world. AMR occurs when microorganisms, such as bacteria, adapt in ways that make currently available treatments for infections less effective.
21.36 million
people who died globally in 2021 had sepsis as an immediate cause of death or in the chain of events leading to their death.
4.71 million
people who died in 2021 suffered from drug-resistant infections, such as lower respiratory, bloodstream, and intra-abdominal infections.
1.14 million
deaths in 2021 were directly caused by AMR.
39 million
people are expected to die from AMR between 2025 and 2050.
Interactive data visuals
Datasets in our catalog
Visit the Global Health Data Exchange (GHDx) to download our estimates and data sources for antimicrobial resistance.
GBD 2021 Bacterial Antimicrobial Resistance Burden Estimates 1990-2021 and Forecasts 2022-2050
Estimate
GBD 2021 Bacterial Antimicrobial Resistance Burden Estimates 1990-2021 and Forecasts 2022-2050
Global Bacterial Antimicrobial Resistance Burden Estimates 2019
Estimate
Global Bacterial Antimicrobial Resistance Burden Estimates 2019
Infections in Oxfordshire Research Database (IORD) 2018
Administrative data
Infections in Oxfordshire Research Database (IORD) 2018
United States MedMined Microbiology Test and In-Patients Hospital Data 2011-2017
Administrative data